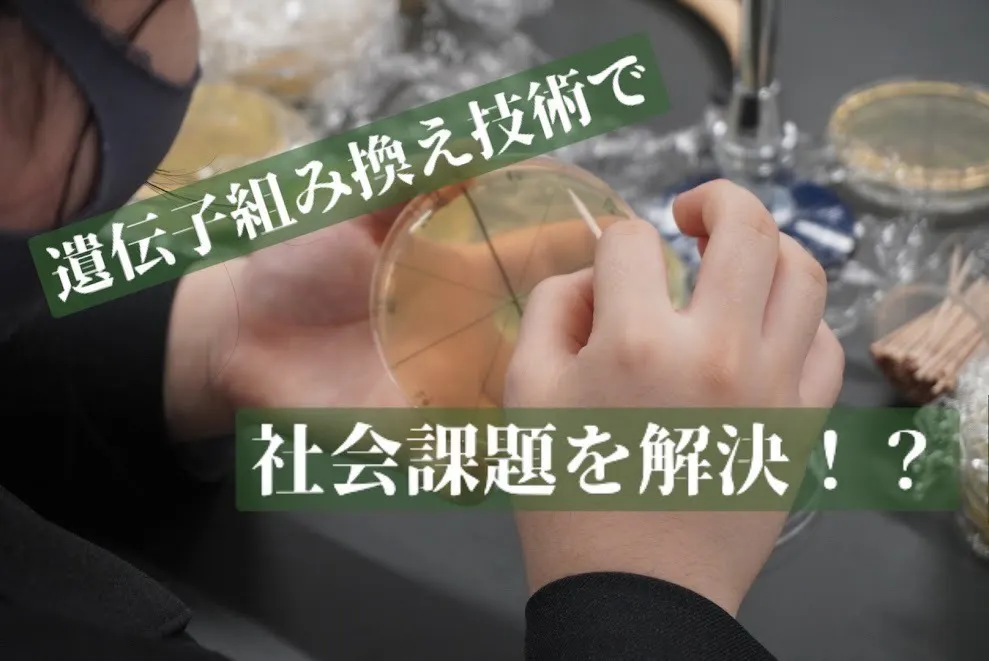
2番目のメイン画像

2024/04/20 16:30

こんにちは!iGEM Grand Tokyoです。
先日、目標金額の50%を達成しました。支援してくださった皆様、本当にありがとうございます。
また、Noteの投稿を始めました。チーム結成の経緯やメンバーそれぞれの経歴、iGEMに対する思いなどを書いています。ぜひ読んでみてください!



現在の支援総額
802,500円
目標金額は900,000円
支援者数
60人
募集終了まで残り
終了
このプロジェクトは、2024/03/25に募集を開始し、 60人の支援により 802,500円の資金を集め、 2024/04/30に募集を終了しました

現在の支援総額
802,500円
89%達成
目標金額900,000円
支援者数60人
このプロジェクトは、2024/03/25に募集を開始し、 60人の支援により 802,500円の資金を集め、 2024/04/30に募集を終了しました

こんにちは!iGEM Grand Tokyoです。
先日、目標金額の50%を達成しました。支援してくださった皆様、本当にありがとうございます。
また、Noteの投稿を始めました。チーム結成の経緯やメンバーそれぞれの経歴、iGEMに対する思いなどを書いています。ぜひ読んでみてください!